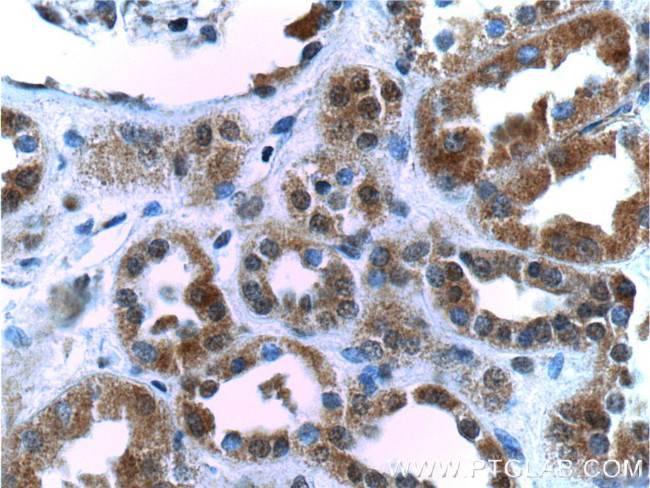
SIX5 Antibody in Immunohistochemistry (Paraffin) (IHC (P))

Search
Proteintech
SIX5 Polyclonal Antibody
{{$productOrderCtrl.translations['antibody.pdp.commerceCard.promotion.promotions']}}
{{$productOrderCtrl.translations['antibody.pdp.commerceCard.promotion.viewpromo']}}
{{$productOrderCtrl.translations['antibody.pdp.commerceCard.promotion.promocode']}}: {{promo.promoCode}} {{promo.promoTitle}} {{promo.promoDescription}}. {{$productOrderCtrl.translations['antibody.pdp.commerceCard.promotion.learnmore']}}
产品信息
22938-1-AP
种属反应
宿主/亚型
分类
类型
抗原
偶联物
形式
浓度
规格
纯化类型
保存液
内含物
保存条件
运输条件
产品详细信息
Immunogen sequence: PLKPETAIS VPEGGLPVAP SPALPEAHAL GTLSAQQPPP AAATTSSTSL PFSPDSPGLL PNFPAPPPEG LMLSPAAVPV WSAGLELSAG TEGLLEAEKG LGTQAPHTVL RLPDPDPEGL LLGATAGGEV DEGLEAEAKV LTQLQSVPVE EPLEL (586-739 aa encoded by BC156983)
靶标信息
Six5 (homeobox protein SIX5), also known as SIX5, BOR2 or DMAHP (DM locus-associated homeodomain protein), is a transcription factor that is expressed in various structures of the adult eye. Localized to the cytoplasm in early development and to the nucleus in the later stages of development, Six5 is involved in regulation of organogenesis and in maintenance of retinal formation. Six5 is able to bind the 5'-TCA[AG][AG]TTNC-3' DNA sequence found in the myogenin and IGFBP5 promoters and, through this binding, can control transcription of the associated mRNA. Six5 is regulated via association with DACH1 (dachshund homolog 1) and is co-activated by the EYA (eyes absent) proteins. Defects in the gene encoding Six5 are the cause of branchiooto- renal syndrome type 2 (BOR2), an autosomal disorder characterized by hearing loss, a deep overbite and myopia. Two isoforms exist due to alternative splicing events.
仅用于科研。不用于诊断过程。未经明确授权不得转售。
篇参考文献 (0)
生物信息学
蛋白别名: DM locus-associated homeodomain protein; dystrophia myotonica-associated homeodomain protein; Homeobox protein SIX5; Sine oculis homeobox homolog 5
基因别名: BOR2; DMAHP; SIX5
UniProt ID: (Human) Q8N196
Entrez Gene ID: (Human) 147912